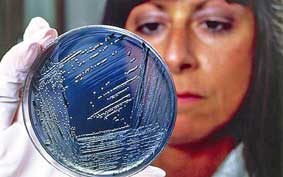

13/08/2010 - 21:50
Khuẩn Salmonella vũ khí mới chống ung thư
-
CDC Cần Thơ đạt 3 giải cuộc thi "Sáng tác sản phẩm truyền thông về môi trường không khói thuốc lá"

- Bệnh viện Đa khoa Hòa Hảo – Medic Cần Thơ kỷ niệm 8 năm thành lập và khánh thành Phòng khám Đa khoa Hòa Hảo – Long Mỹ
- Hiến máu mang đến lợi ích cho cộng đồng và cá nhân
- Review đai lưng bảo vệ cột sống của thương hiệu Haruco
- Điểm sáng ứng dụng công nghệ hiện đại trong chẩn đoán hình ảnh và xét nghiệm của y tế Cần Thơ
- Dấu ấn Hòa Hảo - Medic Cần Thơ trong hành trình 8 năm vì sức khỏe nhân dân miền Tây
-
Sở Y tế TP Cần Thơ công bố quyết định về công tác cán bộ

- 6 loại trái cây tốt cho thận
- Sở Y tế TP Cần Thơ xét công nhận bệnh viện đầu tiên có chất lượng phòng xét nghiệm mức 4
- Vinmec Cần Thơ chính thức áp dụng khám chữa bệnh Bảo hiểm Y tế
- [INFOGRAPHICS] Chức năng, nhiệm vụ, cơ cấu tổ chức của Trạm Y tế cấp xã
- Doanh nhân Singapore tìm cơ hội hợp tác lĩnh vực Y tế tại Cần Thơ
- Khánh thành Phòng khám Bác sĩ gia đình tại Trạm Y tế xã Thạnh Phú và Trạm Y tế xã Trung Hưng
- Những tiến bộ trong điều trị bệnh lý động mạch chủ
- Bệnh viện đầu tiên ở ĐBSCL đạt chứng nhận kiểm định quốc tế theo tiêu chuẩn Hoa Kỳ
- Các bệnh viện ở Cần Thơ diễn tập báo động đỏ ngoại viện
 